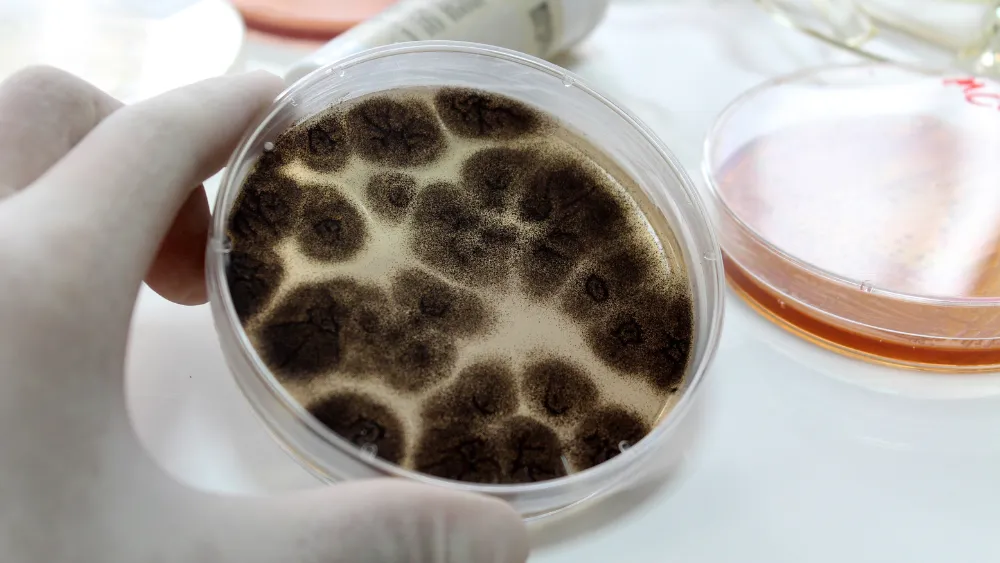
Aspergillus

Héctor Terrones: el adiós al diseñador que vistió los sueños de México
El reconocido creador de moda falleció repentinamente a los 58 años víctima de un infarto fulminante. Su legado, marcado por la elegancia, la teatralidad y el orgullo mexicano, permanece en cada pasarela que lo recuerda.